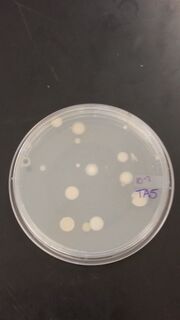

Uploads by Tyler L. Faulkner
From OpenWetWare
Jump to navigationJump to search
This special page shows all uploaded files.
| Date | Name | Thumbnail | Size | Description |
|---|---|---|---|---|
| 17:57, 19 March 2016 | Tyler Food Web.jpg (file) |  |
16 KB | |
| 19:53, 3 March 2016 | Tyler PCR.gif (file) |  |
98 bytes | |
| 02:47, 19 February 2016 | IMG 0363.jpg (file) |  |
475 KB | |
| 01:44, 19 February 2016 | Tyler Faulkner Leaf 3.jpg (file) |  |
12 KB | |
| 01:43, 19 February 2016 | Tyler Faulkner Leaf 2.jpg (file) |  |
13 KB | |
| 01:42, 19 February 2016 | Tyler Faulkner Leaf 4.jpg (file) |  |
16 KB | |
| 01:41, 19 February 2016 | Tyler Faulkner Leaf 5.jpg (file) |  |
6 KB | |
| 01:40, 19 February 2016 | Tyler Faulkner Leaf 1.jpg (file) |  |
19 KB | |
| 02:06, 12 February 2016 | IMG 0347.jpg (file) |  |
1.45 MB | |
| 02:05, 12 February 2016 | IMG 0346.jpg (file) |  |
1.3 MB | |
| 20:47, 4 February 2016 | Tyler Faulkner Gram Stain 4.jpg (file) |  |
638 KB | |
| 20:46, 4 February 2016 | Tyler Faulkner Gram Stain 3.jpg (file) |  |
724 KB | |
| 20:46, 4 February 2016 | Tyler Faulkner Gram Stain 2.jpg (file) |  |
452 KB | |
| 20:45, 4 February 2016 | Tyler Faulkner Gram Stain 1.jpg (file) |  |
697 KB | |
| 04:01, 4 February 2016 | Tyler Faulkner Serial Dilution 10^-5.jpg (file) |  |
3.74 MB | |
| 03:59, 4 February 2016 | Tyler Faulkner Serial Dilution 10^-9.jpg (file) |  |
3.55 MB | |
| 03:59, 4 February 2016 | Tyler Faulkner Serial Dilution 10^-7.jpg (file) | |
3.58 MB | |
| 03:58, 4 February 2016 | Tyler Faulkner Serial Dilution 10^-3.jpg (file) |  |
3.64 MB | |
| 03:57, 4 February 2016 | Tyler Faulkner Serial 10^-7 + T.jpg (file) |  |
3.65 MB | |
| 03:56, 4 February 2016 | Tyler Faulkner Serial 10^-9 + T.jpg (file) |  |
3.61 MB | |
| 03:54, 4 February 2016 | Tyler Faulkner Serial 10^-5 + T.jpg (file) |  |
3.8 MB | |
| 03:52, 4 February 2016 | Tyler Faulkner Serial Dilution 10^-3 + T.jpg (file) |  |
3.8 MB | |
| 03:06, 4 February 2016 | Tyler Faulkner Top Layer.jpg (file) |  |
1.3 MB | |
| 03:05, 4 February 2016 | Tyler Faulkner Transect Middle Layer.jpg (file) |  |
1.11 MB | |
| 03:03, 4 February 2016 | Tyler Faulkner Transect Bottom Layer.jpg (file) |  |
1.3 MB | |
| 02:42, 4 February 2016 | Tyler Faulkner Serial Diluted Procedure.jpg (file) |  |
1.36 MB | |
| 02:41, 4 February 2016 | Tyler Top View Transect IMG 0254.jpg (file) |  |
1.6 MB | |
| 02:40, 4 February 2016 | Tyler IMG 0253.jpg (file) |  |
1.7 MB | |
| 02:39, 4 February 2016 | Tyler Transect IMG 0244.jpg (file) |  |
1.48 MB | |
| 02:37, 4 February 2016 | Tyler Faulkner Transect Sideview.jpg (file) |  |
1.76 MB | |
| 02:30, 4 February 2016 | Tyler Faulkner Lab1 Transect Overview.JPG (file) |  |
1.87 MB | |
| 02:25, 4 February 2016 | Tyler Faulkner Lab 1 Transcect.JPG (file) |  |
1.61 MB | |
| 01:38, 29 January 2016 | IMG 0253.JPG (file) |  |
1.87 MB |